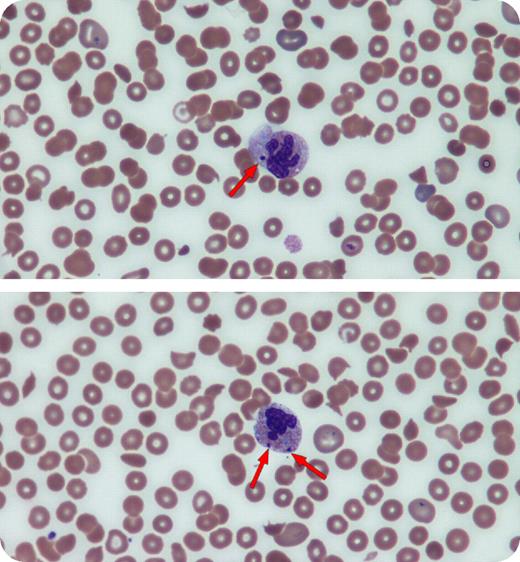
A 40-year-old HIV-positive man was evaluated for fatigue, weakness, fever, and cough. He was not taking any medications. His blood count showed normocytic anemia, leukopenia, and thrombocytopenia (hemoglobin 85.0 g/L, mean corpuscular volume 99 fL, white blood cell count 1.9 × 109/L, platelets 50 × 109/L). His CD4 count was 0.05 ×109/L. Other laboratory tests showed normal B12, folate, thyroid, and liver function tests. Review of his peripheral blood smear revealed the presence of polychromasia, occasional schistocytes, acanthocytes, target cells, and elliptocytes. Several neutrophils showed dysgranulopoietic features that included discrete, basophilic cytoplasmic inclusions (Howell-Jolly body–like inclusions) and occasional hypersegmented cells. The patient refused having bone marrow aspiration and biopsy. Pancytopenia with dysplastic features is common in patients with HIV infection. However, other conditions that cause myelodysplasia, such as nutritional disturbances, myelodysplastic syndrome, and sequelae of chemotherapy or transplantation, must be considered. With HIV infections, the presence of detached nuclear fragments in the cytoplasm of neutrophils that bear a resemblance to the nuclear remnants of red cells known as Howell-Jolly bodies can be found. These unusual inclusions should be differentiated from other intracytoplasmic inclusions, such as those that may be seen in infections or in rare inherited disorders, for example, Chediak-Higashi syndrome.

A 40-year-old HIV-positive man was evaluated for fatigue, weakness, fever, and cough. He was not taking any medications. His blood count showed normocytic anemia, leukopenia, and thrombocytopenia (hemoglobin 85.0 g/L, mean corpuscular volume 99 fL, white blood cell count 1.9 × 109/L, platelets 50 × 109/L). His CD4 count was 0.05 ×109/L. Other laboratory tests showed normal B12, folate, thyroid, and liver function tests. Review of his peripheral blood smear revealed the presence of polychromasia, occasional schistocytes, acanthocytes, target cells, and elliptocytes. Several neutrophils showed dysgranulopoietic features that included discrete, basophilic cytoplasmic inclusions (Howell-Jolly body–like inclusions) and occasional hypersegmented cells. The patient refused having bone marrow aspiration and biopsy. Pancytopenia with dysplastic features is common in patients with HIV infection. However, other conditions that cause myelodysplasia, such as nutritional disturbances, myelodysplastic syndrome, and sequelae of chemotherapy or transplantation, must be considered. With HIV infections, the presence of detached nuclear fragments in the cytoplasm of neutrophils that bear a resemblance to the nuclear remnants of red cells known as Howell-Jolly bodies can be found. These unusual inclusions should be differentiated from other intracytoplasmic inclusions, such as those that may be seen in infections or in rare inherited disorders, for example, Chediak-Higashi syndrome.
A 40-year-old HIV-positive man was evaluated for fatigue, weakness, fever, and cough. He was not taking any medications. His blood count showed normocytic anemia, leukopenia, and thrombocytopenia (hemoglobin 85.0 g/L, mean corpuscular volume 99 fL, white blood cell count 1.9 × 109/L, platelets 50 × 109/L). His CD4 count was 0.05 ×109/L. Other laboratory tests showed normal B12, folate, thyroid, and liver function tests. Review of his peripheral blood smear revealed the presence of polychromasia, occasional schistocytes, acanthocytes, target cells, and elliptocytes. Several neutrophils showed dysgranulopoietic features that included discrete, basophilic cytoplasmic inclusions (Howell-Jolly body–like inclusions) and occasional hypersegmented cells. The patient refused having bone marrow aspiration and biopsy. Pancytopenia with dysplastic features is common in patients with HIV infection. However, other conditions that cause myelodysplasia, such as nutritional disturbances, myelodysplastic syndrome, and sequelae of chemotherapy or transplantation, must be considered. With HIV infections, the presence of detached nuclear fragments in the cytoplasm of neutrophils that bear a resemblance to the nuclear remnants of red cells known as Howell-Jolly bodies can be found. These unusual inclusions should be differentiated from other intracytoplasmic inclusions, such as those that may be seen in infections or in rare inherited disorders, for example, Chediak-Higashi syndrome.
Many Blood Work images are provided by the ASH IMAGE BANK, a reference and teaching tool that is continually updated with new atlas images and images of case studies. For more information or to contribute to the Image Bank, visit www.ashimagebank.org.
This feature is available to Subscribers Only
Sign In or Create an Account Close Modal